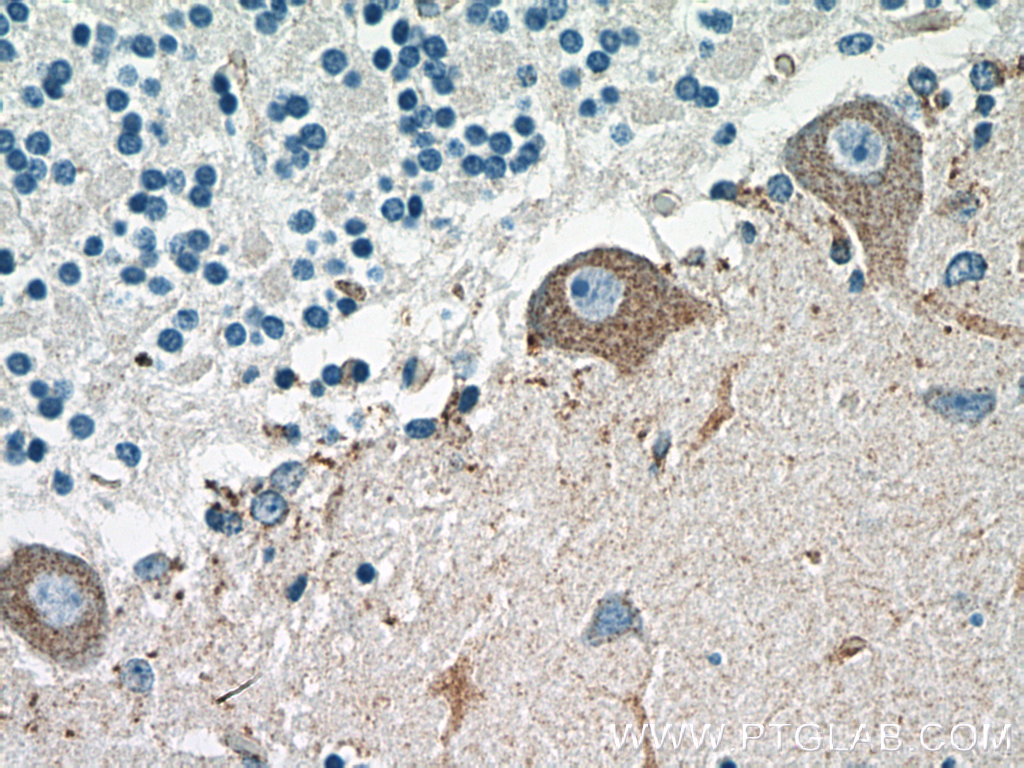

验证数据展示
经过测试的应用
| Positive IP detected in | SH-SY5Y cells |
| Positive IHC detected in | human cerebellum tissue, human prostate hyperplasia tissue Note: suggested antigen retrieval with TE buffer pH 9.0; (*) Alternatively, antigen retrieval may be performed with citrate buffer pH 6.0 |
推荐稀释比
| 应用 | 推荐稀释比 |
|---|---|
| Immunoprecipitation (IP) | IP : 0.5-4.0 ug for 1.0-3.0 mg of total protein lysate |
| Immunohistochemistry (IHC) | IHC : 1:50-1:500 |
| It is recommended that this reagent should be titrated in each testing system to obtain optimal results. | |
| Sample-dependent, Check data in validation data gallery. | |
产品信息
19986-1-AP targets ROBO2 in IP, IHC, ELISA applications and shows reactivity with human samples.
| 经测试应用 | IP, IHC, ELISA Application Description |
| 经测试反应性 | human |
| 免疫原 |
Peptide 种属同源性预测 |
| 宿主/亚型 | Rabbit / IgG |
| 抗体类别 | Polyclonal |
| 产品类型 | Antibody |
| 全称 | roundabout, axon guidance receptor, homolog 2 (Drosophila) |
| 别名 | KIAA1568, ROBO2, Roundabout homolog 2, SAX3 |
| 计算分子量 | 151 kDa |
| GenBank蛋白编号 | NM_002942 |
| 基因名称 | ROBO2 |
| Gene ID (NCBI) | 6092 |
| 偶联类型 | Unconjugated |
| 形式 | Liquid |
| 纯化方式 | Antigen affinity purification |
| UNIPROT ID | Q9HCK4 |
| 储存缓冲液 | PBS with 0.02% sodium azide and 50% glycerol, pH 7.3. |
| 储存条件 | Store at -20°C. Stable for one year after shipment. Aliquoting is unnecessary for -20oC storage. |
背景介绍
ROBO2, also named as KIAA1568, belongs to the immunoglobulin superfamily and ROBO family. ROBO2 is a receptor for SLIT2, and probably SLIT1, which are thought to act as molecular guidance cue in cellular migration, including axonal navigation at the ventral midline of the neural tube and projection of axons to different regions during neuronal development. Defects in ROBO2 are the cause of vesicoureteral reflux type 2 (VUR2). A chromosomal aberration involving ROBO2 is a cause of multiple congenital abnormalities, including severe bilateral VUR with ureterovesical junction defects. The antibody recognizes the C-term of ROBO.